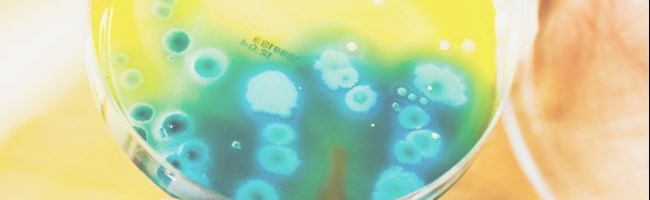

Bakterier i forbindelse med kælderoversvømmelse
Ekstreme vejrhændelser har igennem de senere år været årsag til et stigende antal skybrud med oversvømmelser af kloakvand til følge.
Derfor er der et behov for at belyse, hvilke risici der er forbundet med indtrængende kloakvand i forbindelse med oversvømmelserne – så vi sikrer, at vi håndterer
oversvømmelserne korrekt.
En af konsekvenserne af kloakvand, er forekomsten af bakterier.
I denne folder kan du se mere om hvordan bakterieniveauet ændres efter et skybrud der har medført oversvømmelser i kældre.